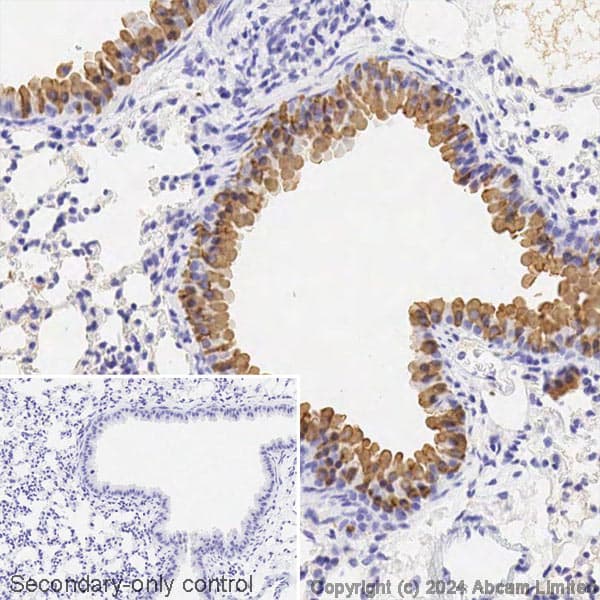
Avidin/Biotin Blocking Kit(ab64212)
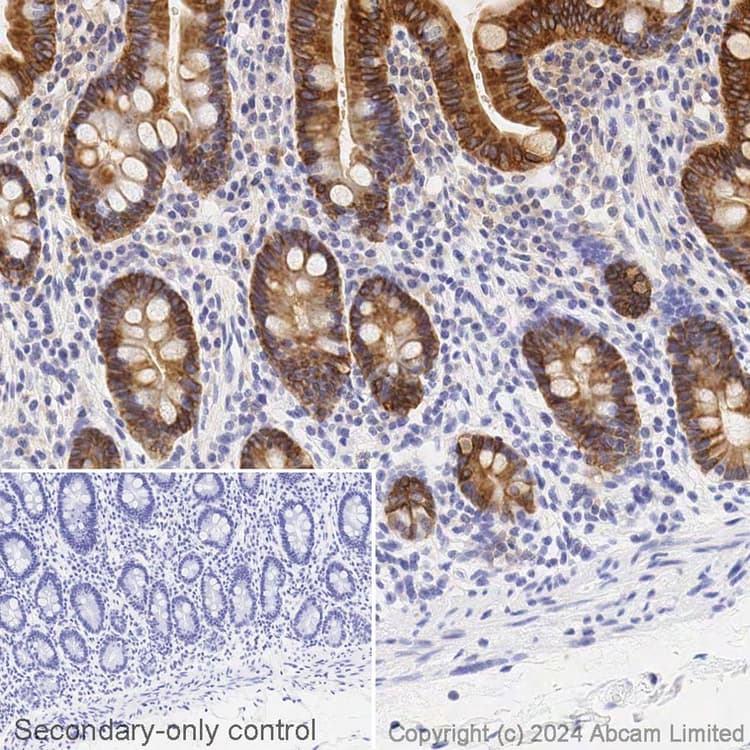
Avidin/Biotin Blocking Kit(ab64212)

Avidin/Biotin Blocking Kit(ab64212)
$undefined

| Shipped At Conditions | Blue Ice |
| Appropriate Long term Storage Conditions | Store at +4°C. |
| Applications | ICC/IF, IHC-Fr, IHC-P |